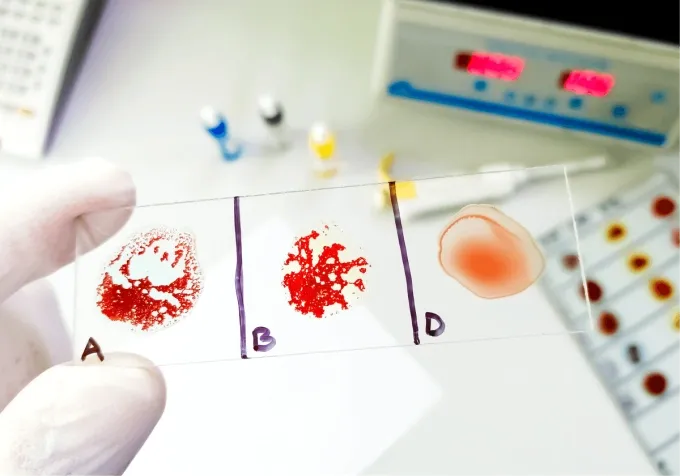
Ph&aacute;t hiện phụ nữ mang nh&oacute;m m&aacute;u &ldquo;Bombay giả&rdquo; cực hiếm, nguy cơ tử vong cao nếu truyền nhầm m&aacute;u O- Ảnh 1.

Bệnh viện trực thuộc Đại học Ninh Ba số 1 ngày 22/1 xác nhận ca bệnh hy hữu nói trên là bà Trịnh, người địa phương, vừa được xuất viện sau ca phẫu thuật thành công. Trước đó, trong quá trình xét nghiệm tiền phẫu, khoa Truyền máu phát hiện kết quả định nhóm máu ABO của bệnh nhân có dấu hiệu bất thường nghiêm trọng khi phản ứng định nhóm xuôi và ngược không trùng khớp. Nhận thấy nguy cơ cao, các bác sĩ lập tức dừng quy trình thông thường và chuyển sang phân tích gene chuyên sâu.
Kết quả giải trình tự gene cho thấy bà Trịnh mang đột biến trên gene FUT1. Về mặt chuyên môn, cơ thể con người cần một “lớp nền” là kháng nguyên H để hình thành các nhóm máu A hoặc B. Ở người mang nhóm máu Bombay giả như bà Trịnh, đột biến gene khiến cơ thể không tạo ra được kháng nguyên H, dù vẫn mang “bản thiết kế” của nhóm máu B. Do thiếu lớp nền này, các xét nghiệm nhanh thông thường không thể nhận diện chính xác, rất dễ chẩn đoán nhầm thành nhóm máu O.
Giới chuyên môn gọi đây là “máu khủng long” vì tỷ lệ xuất hiện cực kỳ hiếm, chỉ khoảng một trên hàng chục nghìn đến hàng trăm nghìn người, thậm chí hiếm hơn cả nhóm máu “gấu trúc” (RhD âm tính). Ngay sau khi xác định chính xác nhóm máu, bệnh viện đã kích hoạt quy trình “báo động đỏ”, tổ chức hội chẩn đa chuyên khoa để xây dựng phương án điều trị an toàn nhất. Ca phẫu thuật sau đó diễn ra thuận lợi nhờ áp dụng các biện pháp cầm máu triệt để, bệnh nhân không cần truyền máu từ người khác.
Theo ông Lục Định Phong, Trưởng khoa Truyền máu Bệnh viện Đại học Ninh Ba số 1, việc truyền máu cho người mang nhóm Bombay giả được xem là “vùng cấm” trong y khoa. Cơ thể những bệnh nhân này sản sinh kháng thể tự nhiên chống lại kháng nguyên H, do đó việc truyền bất kỳ đơn vị máu thông thường nào cũng có thể gây nguy hiểm tính mạng. Đặc biệt, nhóm máu O – vốn được coi là nhóm máu cho phổ biến – lại là loại nguy hiểm nhất đối với bệnh nhân Bombay giả, bởi hồng cầu nhóm O chứa nhiều kháng nguyên H. Nếu truyền nhầm, kháng thể của người nhận sẽ tấn công mạnh mẽ hồng cầu người cho, gây tan máu cấp tính, suy thận và sốc dẫn đến tử vong ngay lập tức.
Trong các tình huống cấp cứu, giải pháp duy nhất cho bệnh nhân mang nhóm máu Bombay giả là sử dụng máu tự thân (được thu gom và dự trữ trước phẫu thuật) hoặc nguồn máu đông lạnh đặc biệt từ ngân hàng máu hiếm quốc gia. Các bác sĩ khuyến cáo người dân, đặc biệt là thân nhân của người mang nhóm máu hiếm, nên chủ động xét nghiệm sàng lọc do tính chất di truyền của biến thể này. Những trường hợp có kết quả nhóm máu khó xác định cần đến các trung tâm huyết học lớn để được làm rõ, đồng thời lưu trữ hồ sơ y tế hoặc tham vấn quy trình gửi máu tự thân nhằm bảo vệ tính mạng trong những tình huống khẩn cấp.

Bình luận
0